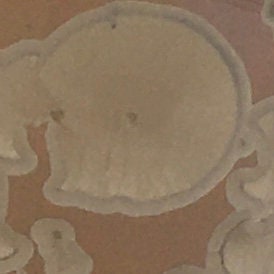

My Store
Keepsake / Pet Cremation Urn - 60 Cubic Inches - SKU 199
Keepsake / Pet Cremation Urn - 60 Cubic Inches - SKU 199
Couldn't load pickup availability
This small hand thrown porcelain urn is 7 inches tall and 5 inches wide. It has a volume of 60 cubic inches and is suitable for a pre cremation weight of up to 60 pounds.
Each urn is packaged with care and attention for shipping. If you require an urn by a certain time, please reach out to me - expedited shipping can easily be arranged for an extra charge.
I hand throw each piece on a potter’s wheel at my studio in Kingston, Ontario, Canada. I opened Black Dog Pottery in 1998 and have been happily making pottery full time for over 20 years. During this time I have been asked to make urns upon special request and for loved ones.
Each urn is thrown and trimmed by hand then fired twice in a kiln. I often spray glazes over each other to achieve the depth of color you see in the images.
The glazes I use have taken many years of testing to develop - crystalline glazes are an especially technical glaze to work with – the crystals form unique shapes during the cooling cycle such that no two pieces are alike. Each piece takes about three weeks to complete from start to finish.
Share